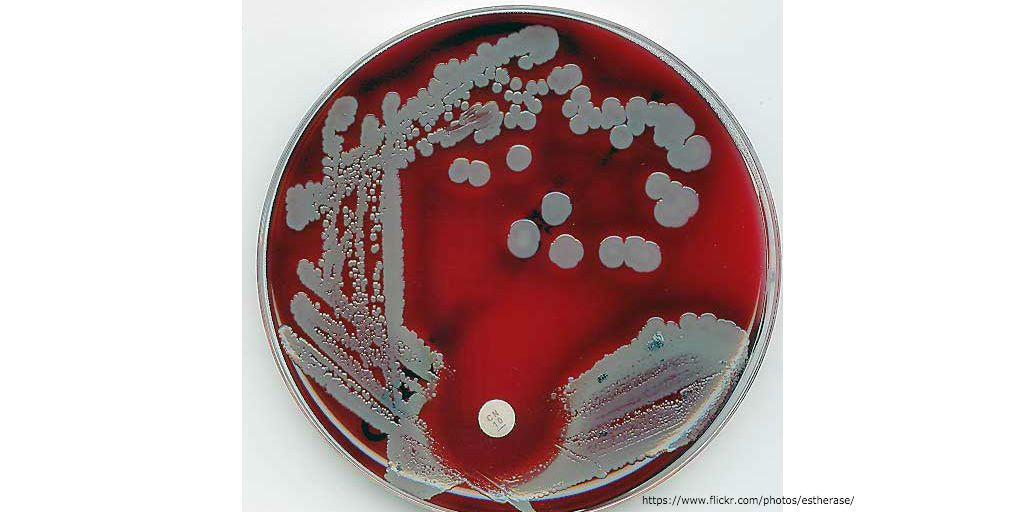

In this episode I’ll: 1. Discuss an article about evaluating the presence of pain in patients with ICU delirium 2. Answer the drug information question: “Does quetiapine reduce the duration of ICU delirium?” 3. Share a resource I use to find information about the prevention and treatment of ICU delrium Subscribe on iTunes, Android, or […]
A free twice-weekly podcast where you can listen to critical care and hospital pharmacy information
Subscribe to the #1 ranked critical care and hospital pharmacy podcast, The Elective Rotation here:
52: Treatment of inpatient hypoglycemia
In this episode I’ll review the inpatient treatment of hypoglycemia. Subscribe on iTunes, Android, or Stitcher Hypoglycemia is a medical emergency To help myself remember and apply medical concepts, I break them down into the most simple terms I can. While most rapid response calls are for problems related to oxygen delivery, hypoglycemia is a problem […]
51: DDAVP for intracranial hemorrhage, re-exposure to heparin after HIT, and bacterial classification resources
In this episode I’ll: 1. Discuss an article recommending DDAVP for intracranial hemorrhage from anti-platelet agents 2. Answer the drug information question: “What should I use to treat a DVT in a patient on CRRT with a recent history of HIT?” 3. Share a resource I use to get an early clue on the identification […]
50: Overdose scenarios in which supportive care is not enough – acetaminophen, methanol, or ethylene glycol poisoning
In this episode I’ll focus on 2 examples of medication overdose that require more than supportive care to treat effectively: 1. Acetaminophen poisoning 2. Methanol & ethylene glycol poisoning Subscribe on iTunes, Android, or Stitcher A special shout out to my kids for the artwork & audio bumper for this episode! Many poisons, few antidotes […]
49: Fixed dosing of 4 factor prothrombin complex concentrate, full dose subcutaneous heparin, and pneumotox
In this episode I’ll: 1. Review an article about fixed dosing of 4-factor prothrombin complex concentrate for emergent warfarin reversal 2. Answer the drug information question: What is the dose of subcutaneous heparin to provide full therapeutic anticoagulation? 3. Share a resource for information about drug-induced & iatrogenic respiratory disease Subscribe on iTunes, Android, or […]
48: Pharmacologic Support In The Treatment Of Shock
In this episode I’ll review the medications used to support the treatment of shock from 12 different etiologies. Subscribe on iTunes, Android, or Stitcher During the treatment of shock, the patient’s life hangs in the balance while the care team quickly delivers interventions to identify and treat the underlying cause. Many of these interventions require […]
47: Augmented renal clearance, endocarditis treatment, and tPA risk vs benefit
In this episode I’ll: 1. Review an article about augmented renal clearance of antibiotics in critically ill patients 2. Answer the drug information question “For a patient with rash to penicillin that is 5 months s/p TAVR and has 4/4 bottles positive for gram positive cocci resembling staph, what antibiotic regimen should be used?” 3. […]
46: Pharmacologic treatments for anaphylaxis
In this episode I’ll review the pharmacologic treatments for anaphylaxis. Subscribe on iTunes, Android, or Stitcher Definition Anaphylaxis is a potentially fatal allergic reaction with a rapid onset. Immunoglobulin E (IgE)-mediated allergic reactions to food, insect stings and medications are the most common triggers for anaphylaxis. As a result of the IgE reaction, mast cells […]
45: Melatonin Decreases Need For ICU Sedation, NSAIDS And GI Prophylaxis, And A Myasthenia Gravis Resource
In this episode I’ll: 1. Review an article about using melatonin to decrease the need for sedation in the ICU 2. Answer the drug information question “How long can I take NSAIDs before I need to take GI prophylaxis? 3. Share a resource I use when taking care of a patient with myasthenia gravis Subscribe on iTunes, […]
44: Status epilepticus management – tips for the pharmacist
In this episode I’ll discuss the management priorities for a hospital pharmacist when caring for a patient with status epilepticus. Subscribe on iTunes, Android, or Stitcher Seizure Whenever I encounter a hospital inpatient with an acute seizure, I make sure that I have IV lorazepam available. Most seizures stop after about 2 minutes. In reality […]
43: Can olanzapine be given IV and the FOAMed subreddit
In this episode I’ll: 1. Review an article I used to answer the drug information question “Can olanzapine be given IV?” 2. Share a resource for finding free open access medical education content Subscribe on iTunes, Android, or Stitcher Article Intravenous droperidol or olanzapine as an adjunct to midazolam for the acutely agitated patient Lead author: Esther […]
42: Initial treatment of severe sepsis and septic shock – tips for the pharmacist
In this episode I’ll talk about tips for the pharmacist in the initial treatment of severe sepsis / septic shock. Subscribe on iTunes, Android, or Stitcher Introduction Severe sepsis is sepsis with organ dysfunction and septic shock is sepsis induced hypotension that remains after adequate fluid resuscitation. Additional criteria for the definitions of severe sepsis […]
- « Previous Page
- 1
- …
- 82
- 83
- 84
- 85
- 86
- …
- 88
- Next Page »